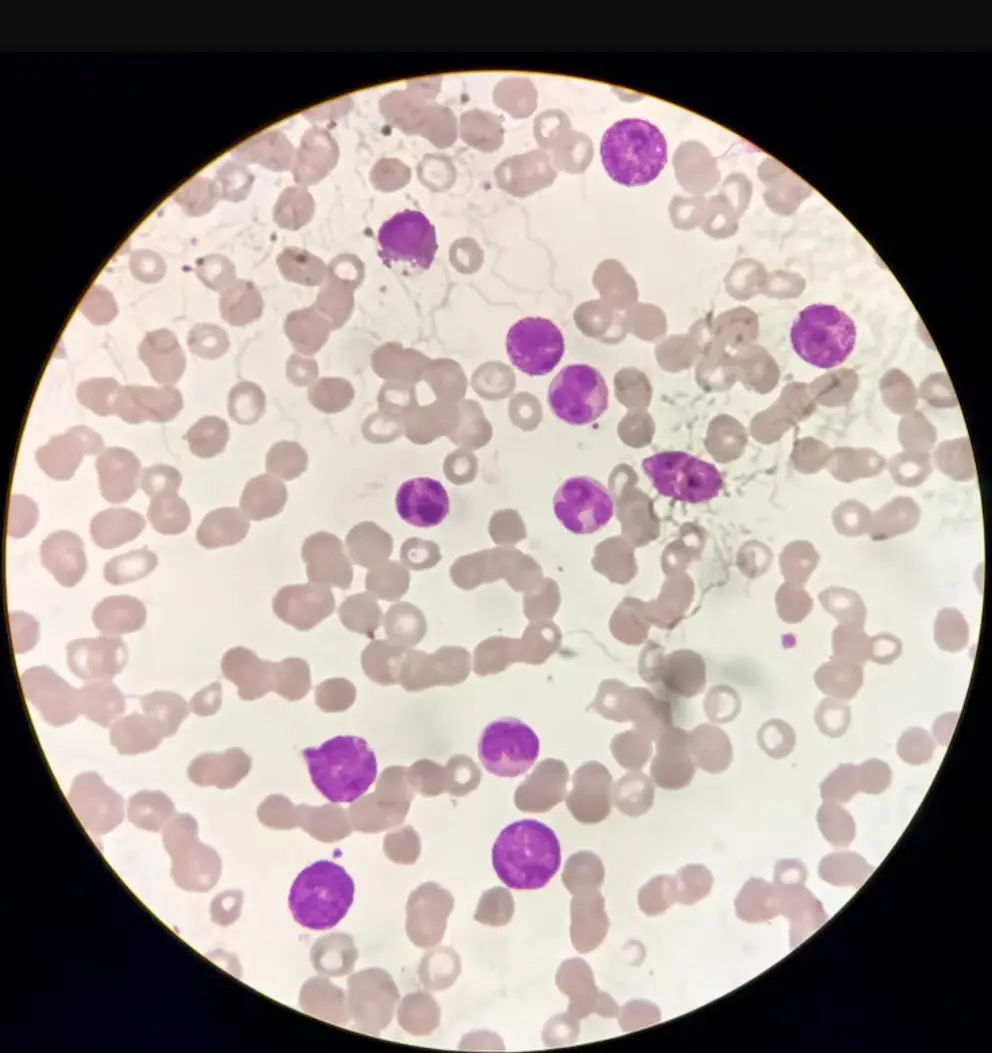

Investigadores descubrieron que el mismo microorganismo que afectó a arqueólogos en excavaciones históricas contiene compuestos prometedores para tratar células cancerosas.

El hongo Aspergillus flavus, responsable de las muertes misteriosas que alimentaron la leyenda de la “maldición de las momias“, podría convertirse en una nueva arma contra la leucemia. Un estudio reciente publicado en Nature Chemical Biology revela que compuestos específicos extraídos de este mismo microorganismo letal muestran efectividad contra células cancerosas, transformando una amenaza histórica en una esperanza terapéutica.
El rastro mortal en las tumbas históricas
Las primeras sospechas sobre el poder letal de este hongo surgieron tras las excavaciones de la tumba del faraón Tutankamón en la década de 1920, cuando varios miembros del equipo arqueológico murieron de forma inexplicable. Los rumores sobre una supuesta maldición de las momias cobraron fuerza hasta los años 1970, cuando un patrón similar se repitió: diez científicos fallecieron después de ingresar a la tumba de Casimir IV en Polonia.
La investigación posterior identificó al Aspergillus flavus como el culpable de estas tragedias. Este hongo tóxico produce esporas que pueden provocar infecciones pulmonares graves, lo que explica las muertes misteriosas que durante décadas se atribuyeron a fuerzas sobrenaturales.

De veneno a medicina: el precedente de la penicilina
La paradoja de que un microorganismo letal pueda convertirse en medicina no es nueva en la historia de la farmacología. Durante casi un siglo, la ciencia extrajo antibióticos de hongos, siendo la penicilina derivada del moho Penicillium el ejemplo más notable. Esta transformación de lo tóxico en terapéutico establece el precedente para el descubrimiento actual.
Según informó Popular Mechanics, los investigadores identificaron compuestos específicos dentro del *A. flavus* llamados péptidos sintetizados ribosomalmente y modificados post-traduccionalmente (RiPPs), que demuestran capacidad para atacar y destruir células de leucemia.
La estructura única de los “asperigimycins”
Después de purificar cuatro RiPPs diferentes, los científicos descubrieron que estas moléculas forman una estructura única de anillos entrelazados, que denominaron “asperigimycins” en honor al hongo de origen. José Larios, hematólogo de trasplantes del Barbara Ann Karmanos Cancer Institute en Detroit, explica que los péptidos son esencialmente “mini proteínas” compuestas por dos o más aminoácidos unidos por enlaces químicos.
Esta configuración molecular particular interfiere con el proceso de división celular de manera específica. Cuando los investigadores añadieron un lípido a una variante del RiPP, el compuesto mostró una efectividad comparable a los medicamentos aprobados por la FDA para tratar leucemia: citarabina y daunorrubicina.

Mecanismo de acción contra el cáncer
“Las células cancerosas se dividen de forma descontrolada. Estos compuestos bloquean la formación de microtúbulos, que son esenciales para la división celular”, explicó Sherry Gao, autora principal del estudio, en un comunicado de prensa.
El mecanismo se basa en la interferencia con un paso crucial de la reproducción celular. Durante la división normal, las células copian su material genético (ADN) y los cromosomas duplicados deben migrar hacia extremos opuestos de la célula, un proceso facilitado por los microtúbulos. El compuesto fúngico interfiere con la organización de estos microtúbulos, lo que provoca una segregación defectuosa de cromosomas y la subsecuente muerte celular necesaria para tratar el cáncer.
La investigación reveló que estos compuestos son específicamente efectivos contra células de leucemia, mientras que muestran poco o ningún efecto sobre células cancerosas de mama, hígado o pulmón.
Perspectivas de expertos y precedentes médicos
“Como oncólogo que trata leucemia, me emociona el hallazgo de un compuesto citotóxico potencialmente nuevo”, afirma Larios, aunque advierte que “todos los compuestos novedosos y potencialmente terapéuticos tienen un camino largo y riguroso por delante”.
Larry Norton, vicepresidente senior del Memorial Sloan Kettering Cancer Center en Nueva York, contextualiza el descubrimiento dentro de un campo bien establecido. “El área de estudiar hongos para determinar medicamentos es un campo bien establecido”, señala Norton al medio, y menciona que además de la penicilina, existen otros antibióticos derivados de hongos, las cefalosporinas para tratar infecciones bacterianas, y las estatinas para reducir el colesterol.
El experto también destaca precedentes de hongos con actividad anticancerosa, incluyendo uno que interfiere con la enzima PI3 kinasa, importante en la resistencia a medicamentos en cánceres hormono-sensibles como el de mama.
Norton advierte sobre los desafíos prácticos de producción a gran escala. Si el medicamento requiere cultivar el hongo y extraer el compuesto químico, especialmente a gran escala, “será una propuesta muy costosa”. La solución implica encontrar formas de sintetizar el compuesto artificialmente para hacer práctico su producción en pureza y volumen suficientes para uso medicinal.

El largo camino hacia la aprobación
El proceso desde el descubrimiento hasta la aprobación de la FDA promedia diez años, según Larios. El nuevo compuesto debe atravesar pruebas preclínicas en líneas celulares y ensayos en animales para determinar eficacia, dosis apropiada y efectos secundarios potenciales. Si estas pruebas resultan eficaces, seguirá un ensayo clínico de fase I para probar seguridad en humanos, antes de múltiples fases adicionales de ensayos clínicos.
Las estadísticas son desalentadoras: según un estudio publicado en el Journal of the National Cancer Institute, solo aproximadamente el 10% de los medicamentos que ingresan a ensayos de fase II logran obtener aprobación de la FDA.
La necesidad de tratamientos alternativos es apremiante, dado que las células cancerosas desarrollan mecanismos de resistencia a terapias existentes. “Mientras algunos cánceres pueden curarse con detección temprana o incluso un número limitado de ciclos de tratamiento, muchos cánceres eventualmente encuentran formas de resistir nuestros medicamentos actuales”, explica Larios al medio. “Cualquier nueva modalidad de tratamiento para el cáncer siempre es emocionante y esperanzadora para pacientes que sufren de cáncer”.
Por Joaquín Bahamonde (Infobae)











